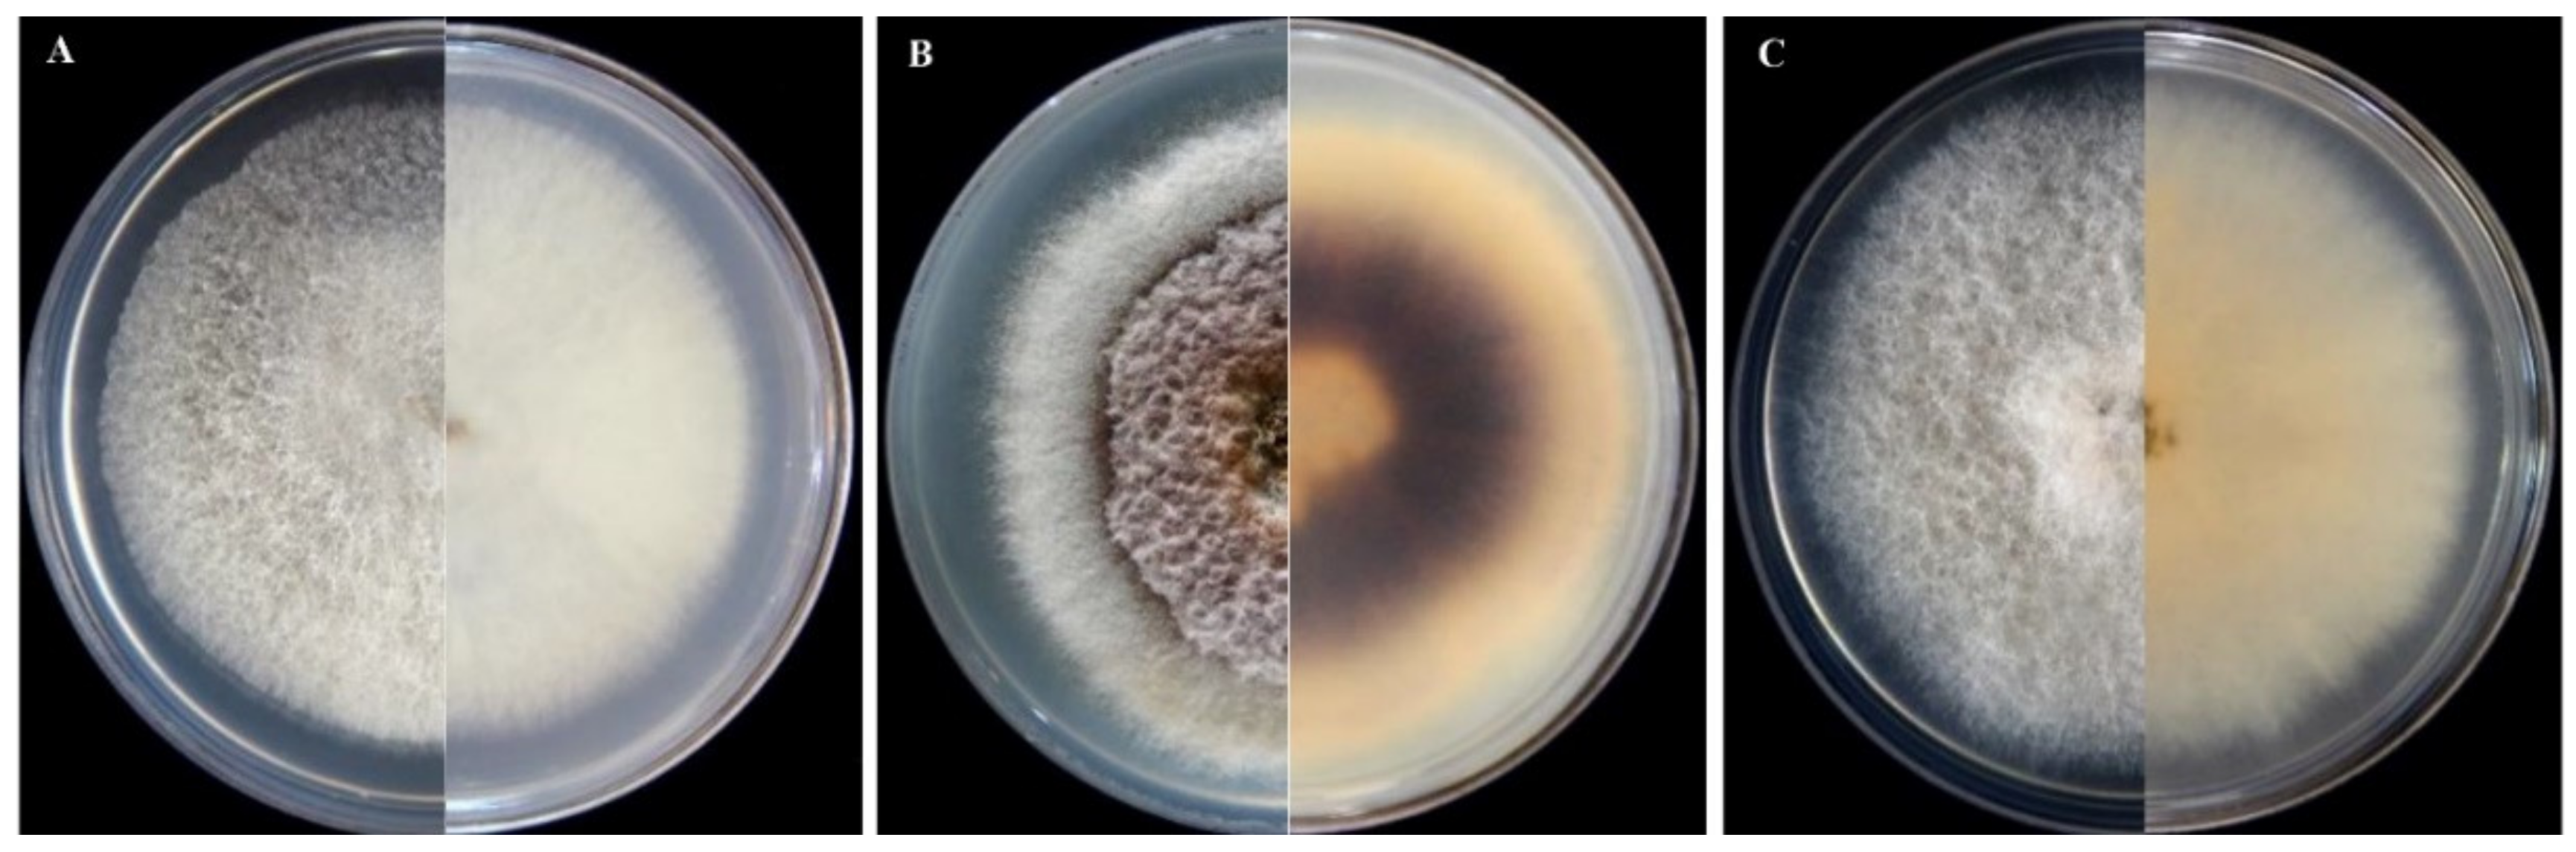
Jof 08 00364 g001

Fusarium and Neocosmospora Species Associated with Rot of Cactaceae and Other Succulent Plants
Abstract
:1. Introduction
2. Materials and Methods
2.1. Isolation of Fungi
2.2. Morphological Characterization
2.3. DNA Extraction, PCR, Sequencing, and Phylogenetic Analyses
2.4. Pathogenicity Tests and Host Range
3. Results
3.1. Sampling
3.2. Morphological Characterization of Isolates of Fusarium and Neocosmospora Species
3.3. Phylogenetic Analysis
3.4. Pathogenicity Tests and Host Range


4. Discussion
5. Conclusions
Author Contributions
Funding
Institutional Review Board Statement
Informed Consent Statement
Data Availability Statement
Acknowledgments
Conflicts of Interest
References
- Eggli, U. Illustrated Handbook of Succulent Plants: Dicotyledons; Springer: Berlin/Heidelberg, Germany, 2004; pp. 1–3. [Google Scholar]
- Albers, F.; Meve, U. Asclepiadaceae. In Illustrated Handbook of Succulent Plants: Aizoaceae A–E.; Albers, F., Meve, U., Eds.; Springer: Berlin/Heidelberg, Germany, 2002; pp. 5–8. [Google Scholar]
- Hartmann, K.E.K. Aizoaceae. In Illustrated Handbook of Succulent Plants: Aizoaceae A–E.; Hartmann, K.E.K., Ed.; Springer: Berlin/Heidelberg, Germany, 2002; pp. 9–268. [Google Scholar]
- Eggli, U. Crassulaceae. In Illustrated Handbook of Succulent Plants: Crassulaceae; Eggli, U., Ed.; Springer: Berlin/Heidelberg, Germany, 2003; pp. 5–8. [Google Scholar]
- Charles, G. Cacti and Succulents: An Illustrated Guide to the Plants and Their Cultivation; Crowood Press: Ramsbury, UK, 2014; 192p. [Google Scholar]
- Christenhusz, M.J.; Byng, J.W. The number of known plant species in the world and its annual increase. Phytotaxa 2016, 261, 201–217. [Google Scholar] [CrossRef] [Green Version]
- Kaplan, H.; Wilson, J.R.U.; Klein, H.; Henderson, L.; Zimmermann, H.G.; Manyama, P.; Ivey, P.; Richardson, D.M.; Novoa, A. A proposed national strategic framework for the management of Cactaceae in South Africa. Bothalia 2017, 47, 1–12. [Google Scholar] [CrossRef]
- Ochoa, M.J.; Barbera, G. History and Economic and Agro-Ecological Importance. In Crop Ecology, Cultivation and Uses of Cactus Pear; Inglese, P., Mondragon, C., Nefzaoui, A., Saenz, C., Eds.; FAO: Rome, Italy; ICARDA: Beirut, Lebanon, 2017; pp. 1–12. [Google Scholar]
- Wick, R.L. Diseases of Holiday Cacti: Schlumbergera and Hatiora. In Handbook of Florists’ Crops Diseases, Handbook of Plant Disease Management Series; McGovern, R., Elmer, W., Eds.; Springer: New York, NY, USA, 2017; pp. 976–986. [Google Scholar]
- Aloi, F.; Giambra, S.; Schena, L.; Surico, G.; Pane, A.; Gusella, G.; Stracquadanio, C.; Burruano, S.; Cacciola, S.O. New insights into scabby canker of Opuntia ficus-indica, caused by Neofusicoccum batangarum. Phytopathol. Mediterr. 2020, 59, 269–284. [Google Scholar]
- Bertetti, D.; Ortu, G.; Gullino, M.L.; Garibaldi, A. Identification of Fusarium oxysporum f. sp. opuntiarum on new hosts of the Cactaceae and Euphorbiaceae families. J. Plant Pathol. 2017, 99, 347–354. [Google Scholar]
- Lombard, L.; van der Merwe, N.A.; Groenewald, J.Z.; Crous, P. Generic concepts in Nectriaceae. Stud. Mycol. 2015, 80, 189–245. [Google Scholar] [CrossRef] [Green Version]
- Sandoval-Denis, M.; Lombard, L.; Crous, P. Back to the roots: A reappraisal of Neocosmospora. Persoonia 2019, 43, 90–185. [Google Scholar] [CrossRef]
- O’Donnell, K. Molecular phylogeny of the Nectria haematococca–Fusarium solani species complex. Mycologia 2000, 92, 919–938. [Google Scholar] [CrossRef]
- Geiser, D.M.; Aoki, T.; Bacon, C.W.; Baker, S.E.; Bhattacharyya, M.K.; Brandt, M.E.; Brown, D.W.; Burgess, L.W.; Chulze, S.; Coleman, J.J.; et al. One fungus, one name: Defining the genus Fusarium in a scientifically robust way that preserves longstanding use. Phytopathology 2013, 103, 400–408. [Google Scholar] [CrossRef] [Green Version]
- O’Donnell, K.; Al-Hatmi, A.M.S.; Aoki, T.; Brankovics, B.; Cano-Lira, J.F.; Coleman, J.J.; de Hoog, G.S.; Di Pietro, A.; Frandsen, R.J.N.; Geiser, D.M.; et al. No to Neocosmospora: Phylogenomic and practical reasons for continued inclusion of the Fusarium solani species complex in the genus Fusarium. Mycosphere 2020, 5, e00810-20. [Google Scholar] [CrossRef]
- Edel-Hermann, V.; Lecomte, C. Current Status of Fusarium oxysporum Formae Speciales and Races. Phytopathology 2019, 109, 512–530. [Google Scholar] [CrossRef] [Green Version]
- Hawa, M.; Salleh, B.; Latiffah, Z. Characterization and pathogenicity of Fusarium proliferatum causing stem rot of Hylocereus polyrhizus in Malaysia. Ann. Appl. Biol. 2013, 163, 269–280. [Google Scholar] [CrossRef]
- Ortu, G.; Bertetti, D.; Gullino, M.L.; Garibaldi, A. A new forma specialis of Fusarium oxysporum on Crassula ovata. J. Plant Pathol. 2013, 95, 33–39. [Google Scholar]
- Ortu, G.; Bertetti, D.; Gullino, M.L.; Garibaldi, A. Fusarium oxysporum f. sp. echeveriae, a novel forma specialis causing crown and stem rot of Echeveria agavoides. Phytopathol. Mediterr. 2015, 54, 64–75. [Google Scholar]
- Masratul Hawa, M.; Nurul Faziha, I.; Nik Mohamad Izham, M.N.; Latiffah, Z. Fusarium fujikuroi associated with stem rot of red-fleshed dragon fruit (Hylocereus polyrhizus) in Malaysia Ann. Appl. Biol. 2017, 170, 434–446. [Google Scholar] [CrossRef]
- Wright, E.R.; Rivera, M.C.; Ghirlanda, A.; Lori, G.A. Basal rot of Hylocereus undatus caused by Fusarium oxysporum in Buenos Aires, Argentina. Plant Dis. 2007, 91, 323. [Google Scholar] [CrossRef]
- Vakalounakis, D.J.; Kavroulakis, N.; Lamprou, K. First report of Fusarium oxysporum causing root and crown rot on barbados aloe in Greece. Plant Dis. 2015, 99, 1649. [Google Scholar] [CrossRef]
- Ramírez-Ramírez, M.; Mancilla-Margalli, N.A.; Meza-Álvarez, L.; Turincio-Tadeo, R.; Guzmán-de Pena, D.; Avila-Miranda, M.E. Epidemiology of Fusarium agave wilt in Agave tequilana Weber var. azul. Plant Protect. Sci. 2017, 53, 144–152. [Google Scholar]
- Ogórek, R.; Piecuch, A.; Kędzior, M. Fusarium oxysporum as a pathogen of pot plants: A case study of the easter lily cactus (Echinopsis oxygona) in Poland. Pol. J. Environ. Stud. 2021, 30, 2701–2708. [Google Scholar] [CrossRef]
- Bertetti, D.; Pensa, P.; Matic, S.; Gullino, M.L.; Garibaldi, A. Stem rot caused by Fusarium oxysporum f. sp. opuntiarum on Mammillaria painteri in Italy. Phytopathol. Mediter. 2020, 59, 365–369. [Google Scholar]
- Safaiefarahani, B.; Mostowfizadeh-Ghalamfarsa, R. Identification and morphological characterization of Fusarium oxysporum f. sp. opuntiarum, the causal agent of basal stem rot of cactus in Fars province. Iran J. Plant Pathol. 2014, 50, 409–410. [Google Scholar]
- Jeffers, S.N.; Martin, S.B. Comparision of two media selective for Phytophthora and Pythium species. Plant Dis. 1986, 70, 1035–1043. [Google Scholar] [CrossRef]
- Choi, Y.W.; Hyde, K.D.; Ho, W.H. Single spore isolation of fungi. Fungal Divers. 1999, 3, 29–38. [Google Scholar]
- Aoki, T.; O’Donnell, K.; Homma, Y.; Lattanzi, A.R. Sudden-death syndrome of soybean is caused by two morphologically and phylogenetically distinct species within the Fusarium solani species complex—F. virguliforme in North America and F. tucumaniae in South America. Mycologia 2003, 95, 660–684. [Google Scholar] [CrossRef] [Green Version]
- Aoki, T.; O’Donnell, K.; Scandiani, M.M. Sudden death syndrome of soybean in South America is caused by four species of Fusarium: Fusarium brasiliense sp. nov., F. cuneirostrum sp. nov., F. tucumaniae and F. virguliforme. Mycologia 2005, 46, 162–183. [Google Scholar] [CrossRef]
- Leslie, J.F.; Summerell, B.A. The Fusarium Laboratory Manual; Blackwell: Ames, IA, USA, 2006; 388p. [Google Scholar]
- Thompson, R.S.; Aveling, T.A.S.; Blanco Prieto, R. A new semi-selective medium for Fusarium graminearum, F. proliferatum, F. subglutinans and F. verticillioides in maize seed. S. Afr. J. Bot. 2013, 84, 94–101. [Google Scholar] [CrossRef]
- Fisher, N.L.; Burgess, L.W.; Toussoun, T.A.; Nelson, P.E. Carnation leaves as a substrate and for preserving cultures of Fusarium species. Phytopathology 1982, 72, 151–153. [Google Scholar] [CrossRef]
- Yilmaz, N.; Sandoval-Denis, M.; Lombard, L.; Visagie, C.M.; Wingfield, B.D.; Crous, P.W. Redefining species limits in the Fusarium fujikuroi species complex. Persoonia 2021, 46, 129–162. [Google Scholar] [CrossRef]
- Nelson, P.E.; Toussoun, T.A.; Cook, R.J. Fusarium: Diseases, Biology and Taxonomy; The Pennsylvania State University Press: University Park, PA, USA, 1982; 474p. [Google Scholar]
- Schena, L.; Abdelfattah, A.; Mosca, S.; Li Destri, G.; Agosteo, G.E.; Cacciola, S.O. Quantitative detection of Colletotrichum godetiae and C. acutatum sensu stricto in the phyllosphere and carposphere of olive during four phenological phases. Eur. J. Plant Pathol. 2017, 149, 337–347. [Google Scholar] [CrossRef]
- O’Donnell, K.; Sutton, D.A.; Rinaldi, M.G.; Sarver, B.A.; Balajee, S.A.; Schroers, H.J.; Summerbel, R.C.; Varg, R.; Crous, P.W.; Zhang, N.; et al. Internet-accessible DNA sequence database for identifying Fusaria from human and animal infections. J. Clin. Microbiol. 2010, 48, 3708–3718. [Google Scholar] [CrossRef] [Green Version]
- Hall, T.A. BioEdit: A user-friendly biological sequence alignment editor and analysis program for Windows 95/98/NT. In Nucleic Acids Symposium Series; Information Retrieval Ltd.: London, UK, 1999; pp. 95–98. [Google Scholar]
- Thompson, J.D.; Gibson, T.J.; Plewniak, F.; Jeanmougin, F.; Higgins, D.G. The ClustalX windows interface: Flexible strategies for multiple sequence alignment aided by quality analysis tools. Nucleic Acids Res. 1997, 25, 4876–4882. [Google Scholar] [CrossRef] [Green Version]
- Ronquist, F.; Huelsenbeck, J.P. MrBayes 3: Bayesian phylogenetic inference under mixed models. Bioinformatics 2003, 19, 1572–1574. [Google Scholar] [CrossRef] [PubMed] [Green Version]
- Salmaninezhad, F.; Mostowfizadeh-Ghalamfarsa, R. Three new Pythium species from rice paddy fields. Mycologia 2019, 111, 274–290. [Google Scholar] [CrossRef] [PubMed]
- Nylander, J.A.; Ronquist, F.; Huelsenbeck, J.P.; Nieves-Aldrey, J. Bayesian phylogenetic analysis of combined data. Systematic Biol. 2004, 53, 47–67. [Google Scholar] [CrossRef] [PubMed] [Green Version]
- Mishra, B.; Ploch, S.; Weiland, C.; Thines, M. TrEase—A Webserver to Infer Phylogenetic Trees with Ease. Available online: http://www.thines-lab.senckenberg.de/trease (accessed on 14 January 2022).
- Stöver, B.C.; Müller, K.F. TreeGraph 2: Combining and visualizing evidence from different phylogenetic analyses. BMC Bioinform. 2010, 11, 1–9. [Google Scholar] [CrossRef] [Green Version]
- TreeBASE. Available online: http://www.treebase.org (accessed on 14 January 2022).
- Sabahi, F. Invenstivigation of Fungal and Fungal-like Soil Borne Pathogens Causal Agents of Oranamentals Mortality in Shiraz. Master’s Thesis, Shiraz University, Shiraz, Iran, 2013. [Google Scholar]
- Westerlund, F.V.; Campbell, R.N.; Kimble, K.A. Fungal root rots and wilt of chickpea in California. Phytopathology 1974, 64, 432–436. [Google Scholar]
- Gerlach, W. Fusarium rot and other fungal diseases of horticulturally important cacti in Germany. Phytopathol. Z. 1972, 74, 197–217. [Google Scholar]
- Van Dam, P.; Fokkens, L.; Schmidt, S.M.; Linmans, J.H.; Kistler, H.C.; Ma, L.J.; Rep, M. Effector profiles distinguish formae speciales of Fusarium oxysporum. Environ. Microbiol. 2016, 18, 4087–4102. [Google Scholar] [CrossRef]
- Lievens, B.; Hanssen, I.M.; Rep, M. Recent developments in the detection and identification of formae speciales and races of Fusarium oxysporum: From pathogenicity testing to molecular diagnostics. In Fusarium Wiltings of Vegetable and Ornamental Crops; Gullino, M.L., Katan, J., Garibaldi, A., Eds.; APS Press: St. Paul, MN, USA, 2017; pp. 47–55. [Google Scholar]
- Duan, Y.; Qu, W.; Chang, S.; Li, C.; Xu, F.; Ju, M.; Zhao, R.; Wang, H.; Zhang, H.; Miao, H. Identification of pathogenicity groups and pathogenic molecular characterization of Fusarium oxysporum f. sp. Sesame in China. Phytopathology 2020, 110, 1093–1104. [Google Scholar] [CrossRef]
- O’Donnell, K.; Kistler, H.C.; Cigelnik, E.; Ploetz, R.C. Multiple evolutionary origin of the fungus causing panama disease of banana: Concordant evidence from nuclear and mitochondrial gene genealogies. Proc. Nat. Acad. Sci. USA 1998, 95, 2044–2049. [Google Scholar] [CrossRef] [Green Version]
- Baayen, R.P.; O’Donnell, K.; Bonants, P.J.M.; Cigelnik, E.; Kroon, L.P.N.M.; Roebroeck, E.J.A.; Waalwijk, C. Gene genealogies and AFLP analyses in the Fusarium oxysporum complex identify monophyletic and non-monophyletic formae speciales causing wilt and rot disease. Phytopathology 2000, 90, 891–900. [Google Scholar] [CrossRef] [Green Version]
- Skovgaard, K.; Nirenberg, H.I.; O’Donnell, K.; Rosendahl, S. Evolution of Fusarium oxysporum f. sp. vasinfectum races inferred from multigene genealogies. Phytopathology 2001, 91, 1231–1237. [Google Scholar]
- Chehri, K. Molecular identification of entomopathogenic Fusarium species associated with Tribolium species in stored grains. J. Invertebr. Pathol. 2017, 144, 1–6. [Google Scholar] [CrossRef]
- Gwinn, K.D.; Hansen, Z.; Kelly, H.; Ownley, B.H. Diseases of Cannabis sativa caused by diverse Fusarium species. Front. Agron. 2022, 3, 796062. [Google Scholar] [CrossRef]
- Narmani, A.; Arzanlou, M.; Babai Ahari, A.; Hatef, H.; Ghasemi, S. First report of fungal soft rot disease caused by Fusarium proliferatum on peanut cactus (Echinopsis chamaecereus) in the world. In Proceedings of the 22nd Iranian Plant Protection Congress, College of Agriculture and Natural Resources, Karaj, Iran, 27–30 August 2016; University of Tehran: Karaj, Iran, 2016; p. 202. [Google Scholar]
- O’Donnell, K.; Sutton, D.A.; Fothergill, A.; McCarthy, D.; Rinaldi, M.G.; Brandt, M.E.; Zhang, N.; Geiser, D.M. Molecular phylogenetic diversity, multilocus haplotype nomenclature, and in vitro antifungal resistance within the Fusarium solani species complex. J. Clin. Microbiol. 2008, 46, 2477–2490. [Google Scholar] [CrossRef] [Green Version]
- Geiser, D.M.; Al-Hatmi, A.M.S.; Aoki, T.; Arie, T.; Balmas, V.; Barnes, I.; Bergstrom, G.C.; Bhattacharyya, M.K.; Blomquist, C.L.; Bowden, R.L.; et al. Phylogenomic analysis of a 55.1 kb 19-gene dataset resolves a monophyletic Fusarium that includes the Fusarium solani species complex. Phytopathology 2021, 111, 1064–1079. [Google Scholar] [CrossRef]
- Costa, S.S.; Matos, K.S.; Tessmann, D.J.; Seixas, C.D.; Pfenning, L.H. Fusarium paranaense sp. nov., a member of the Fusarium solani species complex causes root rot on soybean in Brazil. Fungal Biol. 2016, 120, 51–60. [Google Scholar] [CrossRef]
- Sousa, E.S.; Melo, M.P.; Mota, J.M.; Sousa, E.M.J.; Beserra, J.E.A.; Matos, K.S. First report of Fusarium falciforme (FSSC 3 + 4) causing root rot in lima bean (Phaseolus lunatus L.) in Brazil. Plant Dis. 2017, 101, 1954. [Google Scholar] [CrossRef]
- López-Bautista, V.; Mora-Aguilera, G.; Gutiérrez-Espinosa, M.A.; Mendoza-Ramos, C.; Martínez-Bustamante, V.I.; Coria-Contreras, J.J.; Acevedo-Sánchez, G.; Santana-Peñaloza, B. Morphological and molecular characterization of Fusarium spp. associated to the regional occurrence of wilt and dry bud rot in Agave tequilana. Mex. J. Phytopathol. 2020, 38, 79–106. [Google Scholar] [CrossRef]
- Nesic, K.; Ivanovic, S.; Nesic, V. Fusarial toxins: Secondary metabolites of Fusarium fungi. Rev. Environ. Contam. Toxicol. 2014, 228, 101–120. [Google Scholar]
- Chang, H.-X.; Domier, L.L.; Radwan, O.; Yendrek, C.R.; Hudson, M.E.; Hartman, G.L. Identification of multiple phytotoxins produced by Fusarium virguliforme including a phytotoxic effector (FvNIS1) associated with sudden death syndrome foliar symptoms. MPMI 2016, 29, 96–108. [Google Scholar] [CrossRef] [Green Version]
- Perincherry, L.; Lalak-Kańczugowska, J.; Stępień, Ł. Fusarium-produced mycotoxins in plant-pathogen interactions. Toxins 2019, 11, 664. [Google Scholar] [CrossRef] [Green Version]
- Bentivenga, G.; Spina, A.; Ammar, K.; Allegra, M.; Cacciola, S.O. Screening of durum wheat (Triticum turgidum L. subsp. durum (Desf.) Husn.) Italian cultivars for susceptibility to fusarium head blight incited by Fusarium graminearum. Plants 2021, 10, 68. [Google Scholar]
- Stracquadanio, C.; Luz, C.; La Spada, F.; Meca, G.; Cacciola, S.O. Inhibition of mycotoxigenic fungi in different vegetable matrices by extracts of Trichoderma Species. J. Fungi 2021, 7, 445. [Google Scholar] [CrossRef]
- Somma, S.; Petruzzella, A.L.; Logrieco, A.F.; Meca, G.; Cacciola, S.O.; Moretti, A. Phylogenetic analyses of Fusarium graminearum strains from cereals in Italy, and characterisation of their molecular and chemical chemotypes. Crop Pasture Sci. 2014, 65, 52–60. [Google Scholar] [CrossRef]
- Nirmaladevi, D.; Venkataramana, M.; Srivastava, R.; Uppalapati, S.R.; Gupta, V.K.; Yli-Mattila, T.; Tsui, K.M.C.; Srinivas, C.; Niranjana, S.R.; Chandra, N.S. Molecular phylogeny, pathogenicity and toxigenicity of Fusarium oxysporum f. sp. lycopersici. Sci. Rep. 2016, 6, 21367. [Google Scholar] [CrossRef] [Green Version]
- Pasquali, M.; Beyer, M.; Logrieco, A.; Audenaert, K.; Balmas, V.; Basler, R.; Boutigny, A.-L.; Chrpová, J.; Czembor, E.; Gagkaeva, T.; et al. A European database of Fusarium graminearum and F. culmorum trichothecene genotypes. Front. Microbiol. 2016, 7, 406. [Google Scholar] [CrossRef] [Green Version]
- Sutherland, M.L.; Pegg, G.F. Purification of a toxin from Fusarium oxysporum f. sp. lycopersici race 1. Physiol. Mol. Plant Pathol. 1995, 46, 243–254. [Google Scholar] [CrossRef]
- Aloi, F.; Riolo, M.; Sanzani, S.M.; Mincuzzi, A.; Ippolito, A.; Siciliano, I.; Pane, A.; Gullino, M.L.; Cacciola, S.O. Characterization of Alternaria Species Associated with Heart Rot of Pomegranate Fruit. J. Fungi 2021, 7, 172. [Google Scholar] [CrossRef]
- Masi, M.; Aloi, F.; Nocera, P.; Cacciola, S.O.; Surico, G.; Evidente, A. Phytotoxic metabolites isolated from Neofusicoccum batangarum, the causal agent of the scabby canker of cactus pear (Opuntia ficus-indica L.). Toxins 2020, 12, 126. [Google Scholar] [CrossRef] [PubMed] [Green Version]
- Ćeranić, A.; Svoboda, T.; Berthiller, F.; Sulyok, M.; Samson, J.M.; Güldener, U.; Schuhmacher, R.; Adam, G. Identification and functional characterization of the gene cluster responsible for fusaproliferin biosynthesis in Fusarium proliferatum. Toxins 2021, 13, 468. [Google Scholar] [CrossRef]
- Lievens, B.; Houterman, P.M.; Rep, M. Effector gene screening allows unambiguous identification of Fusarium oxysporum f. sp. lycopersici races and discrimination from other formae speciales. FEMS Microbiol. Lett. 2009, 300, 201–215. [Google Scholar] [PubMed] [Green Version]
- Taylor, A.; Vágány, V.; Jackson, A.C.; Harrison, R.J.; Rainoni, A.; Clarkson, J.P. Identification of pathogenicity-related genes in Fusarium oxysporum f. sp. cepae. Mol. Plant Pathol. 2015, 17, 1032–1047. [Google Scholar] [CrossRef] [PubMed] [Green Version]
- Pangallo, S.; Li Destri Nicosia, M.G.; Agosteo, G.E.; Abdelfattah, A.; Romeo, F.V.; Cacciola, S.O.; Rapisarda, P.; Schena, L. Evaluation of a pomegranate peel extract (PGE) as alternative mean to control olive anthracnose. Phytopathology 2017, 107, 1462–1467. [Google Scholar] [CrossRef] [PubMed] [Green Version]

| Species | Isolates | Collection Date | Location | Longitude | Latitude | Matrix a | GenBank Accession No. b |
|---|---|---|---|---|---|---|---|
| Neocosmospora falciformis | |||||||
| FNol01 | October 2018 | Bajgah | 29°43′23.3″ N | 52°35′30.0″ E | NoLe crown | OM801788 | |
| FGyh01 | February 2018 | Ghast-e Dasht | 29°39′33.0″ N | 52°28′50.9″ E | GyHo stem | OM801786 | |
| FMab01 | September 2018 | Ghast-e Dasht | 29°39′33.0″ N | 52°28′50.9″ E | MaBe crown | N/A | |
| FNol05 | April 2018 | Bajgah | 29°43′23.3″ N | 52°35′30.0″ E | NoLe crown | N/A | |
| FEcp01 | September 2018 | Ghast-e Dasht | 29°39′27.6″ N | 52°28′54.3″ E | EaPe crown | N/A | |
| FEcg01 | September 2018 | Ghast-e Dasht | 29°39′31.7″ N | 52°28′51.1″ E | EaGr crown | N/A | |
| Fgyb03 | October 2018 | Bajgah | 29°43′23.3″ N | 52°35′30.0″ E | GyDa stem | N/A | |
| FAeg01 | February 2018 | Ghast-e Dasht | 29°39′27.6″ N | 52°28′54.3″ E | AeGo crown | OM801787 | |
| FGya01 | February 2018 | Ghast-e Dasht | 29°39′27.6″ N | 52°28′54.3″ E | GyAi crown | N/A | |
| FGya02 | February 2018 | Ghast-e Dasht | 29°38′40.0″ N | 52°28′05.2″ E | CeEu root | N/A | |
| FCee02 | February 2018 | Ghast-e Dasht | 29°39′30.4″ N | 52°28′52.8″ E | EaGr crown | N/A | |
| FEcg11 | October 2018 | Sadra | 29°48′52.4″ N | 52°29′26.0″ E | EaGr stem | N/A | |
| FEcg02 | October 2018 | Sadra | 29°48′52.4″ N | 52°29′26.0″ E | EaGr stem | N/A | |
| FEcm01 | September 2018 | Ghast-e Dasht | 29°39′27.6″ N | 52°28′54.3″ E | EcMi root | N/A | |
| FAeg11 | September 2018 | Ghast-e Dasht | 29°39′31.7″ N | 52°28′51.1″ E | AeGo root | N/A | |
| FEcg21 | September 2018 | Ghast-e Dasht | 29°39′33.0″ N | 52°28′50.9″ E | EcGi root | N/A | |
| FMab11 | September 2018 | Ghast-e Dasht | 29°39′33.0″ N | 52°28′50.9″ E | MaBe root | N/A | |
| Fusarium oxysporum f. sp. opuntiarum | |||||||
| OGyf01 | February 2018 | Ghast-e Dasht | 29°39′27.6″ N | 52°28′54.3″ E | GyFe stem | OM801795 | |
| OAsm01 | February 2018 | Ghast-e Dasht | 29°38′40.0″ N | 52°28′04.7″ E | AsMy stem | N/A | |
| OFel01 | September 2018 | Ghast-e Dasht | 29°39′33.0″ N | 52°28′50.9″ E | FeAl stem | N/A | |
| OEeh31 | September 2018 | Ghast-e Dasht | 29°39′33.0″ N | 52°28′50.9″ E | EaHo crown | N/A | |
| OAsm11 | September 2018 | Ghast-e Dasht | 29°39′33.0″ N | 52°28′50.9″ E | AsMy stem | N/A | |
| OMae04 | October 2018 | Bajgah | 29°43′23.3″ N | 52°35′30.0″ E | MaEl crown | N/A | |
| ONos03 | October 2018 | Bajgah | 29°43′23.3″ N | 52°35′30.0″ E | NoRu crown | OM801797 | |
| ONos04 | July 2018 | Bajgah | 29°43′23.3″ N | 52°35′30.0″ E | NoRu crown | OM801798 | |
| OEep02 | October 2018 | Bajgah | 29°43′23.3″ N | 52°35′30.0″ E | EePh stem | OM801793 | |
| OEcg36 | February 2018 | Ghast-e Dasht | 29°39′27.6″ N | 52°28′54.3″ E | EaGr crown | N/A | |
| OMas01 | September 2018 | Ghast-e Dasht | 29°38′40.0″ N | 52°28′05.2″ E | MaSp root | N/A | |
| OAsm21 | April 2018 | Ghast-e Dasht | 29°39′31.7″ N | 52°28′51.1″ E | AsMy root | OM801790 | |
| OEcg01 | July 2018 | Sadra | 29°48′52.4″ N | 52°29′26.0″ E | EaGr crown | N/A | |
| OEcv01 | July 2018 | Sadra | 29°48′52.4″ N | 52°29′26.0″ E | EeNi crown | N/A | |
| OEcp01 | September 2018 | Ghast-e Dasht | 29°39′41.6″ N | 52°28′43.6″ E | EePh root | N/A | |
| OEep01 | October 2018 | Bajgah | 29°43′23.3″ N | 52°35′30.0″ E | EePh stem | N/A | |
| OFel11 | February 2018 | Ghast-e Dasht | 29°39′33.0″ N | 52°28′50.9″ E | FeAl crown | OM801794 | |
| OEep11 | July 2018 | Ghast-e Dasht | 29°39′33.0″ N | 52°28′50.9″ E | EaPe soil | N/A | |
| OEag13 | July 2018 | Bajgah | 29°43′23.3″ N | 52°35′30.0″ E | EaGr crown | N/A | |
| OMap01 | February 2018 | Ghast-e Dasht | 29°39′30.4″ N | 52°28′52.8″ E | MaGr crown | OM801796 | |
| OGym01 | February 2018 | Ghast-e Dasht | 29°39′33.0″ N | 52°28′50.9″ E | MaGr crown | N/A | |
| OEcp11 | February 2018 | Ghast-e Dasht | 29°38′40.0″ N | 52°28′05.2″ E | EaPe root | N/A | |
| OEcp21 | September 2018 | Ghast-e Dasht | 29°39′33.0″ N | 52°28′50.9″ E | EaPe crown | N/A | |
| OAea01 | October 2018 | Bajgah | 29°43′23.3″ N | 52°35′30.0″ E | AeAr crown | N/A | |
| OAsm31 | June 2018 | Ghast-e Dasht | 29°38′40.0″ N | 52°28′05.2″ E | AsMy crown | OM801791 | |
| ONol02 | September 2018 | Ghast-e Dasht | 29°39′27.6″ N | 52°28′54.3″ E | NoLe crown | N/A | |
| OMam01 | September 2018 | Ghast-e Dasht | 29°38′40.0″ N | 52°28′05.2″ E | MaMa stem | N/A | |
| OMap03 | October 2018 | Bajgah | 29°43′23.3″ N | 52°35′30.0″ E | MaPe root | N/A | |
| OMap04 | October 2018 | Bajgah | 29°43′23.3″ N | 52°35′30.0″ E | MaPe root | N/A | |
| OGyd01 | July 2018 | Sadra | 29°48′52.4″ N | 52°29′26.0″ E | GyDa stem | N/A | |
| OMaj01 | July 2018 | Sadra | 29°48′52.4″ N | 52°29′26.0″ E | MaJa stem | N/A | |
| OEcg42 | February 2018 | Ghast-e Dasht | 29°38′40.0″ N | 52°28′05.2″ E | EaGr stem | OM801792 | |
| ONom01 | February 2018 | Ghast-e Dasht | 29°39′30.4″ N | 52°28′52.8″ E | NoMa root | N/A | |
| ONom02 | February 2018 | Ghast-e Dasht | 29°39′27.6″ N | 52°28′54.3″ E | NoMa root | N/A | |
| ONom05 | February 2018 | Ghast-e Dasht | 29°38′40.0″ N | 52°28′04.7″ E | NoMa root | N/A | |
| OMap05 | February 2018 | Ghast-e Dasht | 29°39′27.6″ N | 52°28′54.3″ E | MaPr root | N/A | |
| OMag02 | February 2018 | Ghast-e Dasht | 29°39′30.4″ N | 52°28′52.8″ E | MaGr root | N/A | |
| OGyd11 | February 2018 | Ghast-e Dasht | 29°39′33.0″ N | 52°28′50.9″ E | GyDa root | N/A | |
| Fusarium proliferatum | |||||||
| PEcg29 | February 2018 | Ghast-e Dasht | 29°39′27.6″ N | 52°28′54.3″ E | EaGr crown | OM801789 | |
| PEcg02 | February 2018 | Ghast-e Dasht | 29°39′27.6″ N | 52°28′54.3″ E | EaGr crown | N/A | |
| PFeg01 | February 2018 | Ghast-e Dasht | 29°39′31.7″ N | 52°28′51.1″ E | FeGa root | N/A | |
| PAsm09 | February 2018 | Ghast-e Dasht | 29°39′30.4″ N | 52°28′52.8″ E | AsMy stem | N/A | |
| PMap01 | February 2018 | Ghast-e Dasht | 29°39′33.0″ N | 52°28′50.9″ E | MaPr stem | N/A | |
| PMav02 | February 2018 | Ghast-e Dasht | 9°39′27.6″ N | 52°28′54.3″ E | MaVe crown | N/A | |
| PNor01 | February 2018 | Ghast-e Dasht | 29°39′41.4″ N | 52°28′43.7″ E | NoRu root | N/A | |
| Fungal Species | ||
|---|---|---|
| Neocosmospora falciformis | Fusarium oxysporum f. sp. opuntiarum | Fusarium proliferatum |
| Test Plants | ||
| Aeonium arboreum (L.) Webb and Berthel | Aeonium arboreum (L.) Webb and Berthel | Astrophytum myriostigma (Zucc.) Lem. |
| Astrophytum asterias (Zucc.) Lem. | Astrophytum asterias (Zucc.) Lem. | Cephalocereus euphorbioides Britton and Rose |
| Echinocactus grusonii Hildm. | Astrophytum myriostigma (Zucc.) Lem. | Cereus jamacaru DC. |
| Ferocactus glaucescens (DC.) Britton and Rose | Braunsia apiculata (Kensit) L. Bolus | Echinocactus grusonii Hildm. |
| Ferocactus macrodiscus Britton and Rose | Carnegiea polylopha Hunt (syn. Neobuxbaumia polylopha (DC.) Bauckeberg) | Mammillaria gracilis Pfeiff. Mammillaria jaliscana Britton and Rose |
| Mammillaria bernalensis Repp. | Cereus jamacaru DC. | Mammillaria pottsii Scheer ex Salm–Dyck |
| Mammillaria gracilis Pfeiff. | Echinocactus grusonii Hildm | Mammillaria prolifera (Mill.) Haw. |
| Mammillaria prolifera (Mill.) Haw. | Echinocereus nivosus Glass and Foster | |
| Mammillaria spinosissima Lem. | Ferocactus emoryi Orcutt | |
| Opuntia ficus-indica (L.) Mill. | Ferocactus foetens Britton and Rose | |
| Ferocactus glaucescens Britton and Rose | ||
| Ferocactus macrodiscus Britton and Rose | ||
| Gymnocalycium mihanovichii Fric ex Gürke) Britton & Rose | ||
| Hamatocactus setispinus (Engelm.) Britton and Rose | ||
| Mammillaria gracilis Pfeiff. | ||
| Mammillaria jaliscana Britton and Rose | ||
| Mammillaria matudae Bravo | ||
| Mammillaria pottsii Scheer ex Salm–Dyck | ||
| Mammillaria spinosissima (Kuntze) Lem. | ||
| Opuntia fragilis (Nutt.) Haw. | ||
| Sedum angelina L. | ||
Publisher’s Note: MDPI stays neutral with regard to jurisdictional claims in published maps and institutional affiliations. |
© 2022 by the authors. Licensee MDPI, Basel, Switzerland. This article is an open access article distributed under the terms and conditions of the Creative Commons Attribution (CC BY) license (https://creativecommons.org/licenses/by/4.0/).
Share and Cite
Kamali-Sarvestani, S.; Mostowfizadeh-Ghalamfarsa, R.; Salmaninezhad, F.; Cacciola, S.O. Fusarium and Neocosmospora Species Associated with Rot of Cactaceae and Other Succulent Plants. J. Fungi 2022, 8, 364. https://doi.org/10.3390/jof8040364
Kamali-Sarvestani S, Mostowfizadeh-Ghalamfarsa R, Salmaninezhad F, Cacciola SO. Fusarium and Neocosmospora Species Associated with Rot of Cactaceae and Other Succulent Plants. Journal of Fungi. 2022; 8(4):364. https://doi.org/10.3390/jof8040364
Chicago/Turabian StyleKamali-Sarvestani, Sahar, Reza Mostowfizadeh-Ghalamfarsa, Fatemeh Salmaninezhad, and Santa Olga Cacciola. 2022. "Fusarium and Neocosmospora Species Associated with Rot of Cactaceae and Other Succulent Plants" Journal of Fungi 8, no. 4: 364. https://doi.org/10.3390/jof8040364
APA StyleKamali-Sarvestani, S., Mostowfizadeh-Ghalamfarsa, R., Salmaninezhad, F., & Cacciola, S. O. (2022). Fusarium and Neocosmospora Species Associated with Rot of Cactaceae and Other Succulent Plants. Journal of Fungi, 8(4), 364. https://doi.org/10.3390/jof8040364

